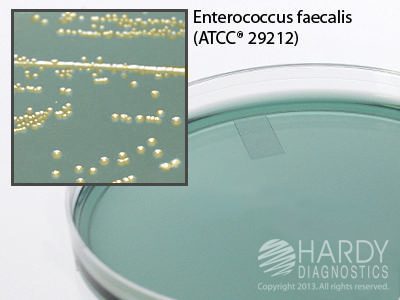

Bioreagents
Lauryl Tryptose Broth with MUG (Durham Tube), Hardy Diagnostics – K238, Pack of 20, Lauryl Tryptose w/MUG
$68.60BROTH LAURYL TRYPTOSE WITH MUG 10ML TUBE
HardyCHROM MRSA/HardyCHROM Staph Aureus Biplate, Hardy Diagnostics – J35, Pack of 10, HC MRSA/HC S. au
$64.28MRSA /STAPH AUREUS HARDYCHROM 15X100 MM
CLED Agar, Hardy Diagnostics – G223, Pack of 10, CLED Agar
$23.06CLED AGAR 15X100 MM FOR IDENT URNE PTHGN
LEICA-PARAPLAST PLUS SURGIPATH 8 X 1KG – 39602004, 8×1 kg
$126.29LEICA-PARAPLAST PLUS SURGIPATH 8 X 1KG
DYE POWDERED STAIN HAEMATOXYLIN 1 BOTTLE – 3803815, 1 bottle
$143.62DYE POWDERED STAIN HAEMATOXYLIN 1BOTTLE
SelecTech Define Staining System, Leica – 3803598, 4×1 gal., SelecTech Ready-To-Use Blue Buffer 8 – Define MX-aq
$259.08BUFFER SELECTECH AQUA DEFINE MX RTU
SelecTech Define Staining System, Leica – 3802918, 4×1 gal., Blue buffer SelecTech ready-to-use
$250.30BUFFER SELECTECH READY-TO-USE BLUE
STAIN G-6 SECONDARY-COUNTER ORANGE 6 GAL – 3801660, 6 gal.
$142.32STAIN G-6 SECONDARY-COUNTER ORANGE 6 GAL
SelecTech Define Staining System, Leica – 3801570, 500 ml, Hematoxylin
$87.65STAINING HEMATOXYLIN 500ML
Surgipath Carbon Steel Scalpel Handles, Leica – 38DI36419, Handle #4 for #22 and #22B Blades
$52.77HANDLE POINT/BNT CB STL NO.22/NO.22B BLD
Surgipath Dissection Forceps, Leica – 38DI18031, Splinter Dissection Forceps, Straight
$27.69FORCEPS SPLINTER / POTTS-SMITH SMTH 7IN